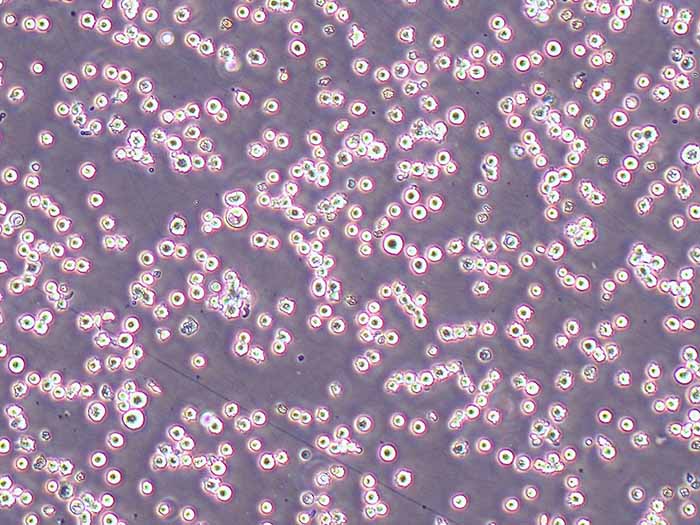
NCI-H716细胞图片

相关产品推荐更多 >
万千商家帮你免费找货
0 人在求购买到急需产品
- 详细信息
- 询价记录
- 文献和实验
- 技术资料
- 品系:
细胞系
- 细胞类型:
详见说明书
- 肿瘤类型:
详见说明书
- 供应商:
上海博尔森生物科技有限公司
- 库存:
大量
- 英文名:
Human Colon Cancer Cells
- 生长状态:
悬浮生长
- 年限:
永久
- 运输方式:
干冰或常温
- 器官来源:
器官:盲肠; 疾病:结直肠腺癌
- 是否是肿瘤细胞:
详见说明书
- 细胞形态:
上皮细胞样,悬浮,少量贴壁
- 免疫类型:
详见说明书
- 物种来源:
人
- 相关疾病:
详见说明书
- 组织来源:
器官:盲肠; 疾病:结直肠腺癌
- 规格:
株
规格:1×106cells/T25或1mL冻存管 形态:上皮细胞样,悬浮,少量贴壁
培养基:RPMI-1640+10%FBS+PS
传代比例:1:2至1:3,每周 3 次

| 一、细胞基本属性 | ||||
| 细胞名称 | NCI-H716人结直肠腺癌细胞(STR鉴定正确) | |||
| 细胞别称 | NCI H716; H716; H-716; NCIH716;人结直肠腺癌细胞 | |||
| 种属来源 | 人 | |||
| 年龄性别 | 男;33岁 | |||
| 组织来源 | 器官:盲肠; 疾病:结直肠腺癌 | |||
| 生长特性 | 悬浮生长 | |||
| 细胞形态 | 上皮细胞样,悬浮,少量贴壁 | |||
| 背景简介 | NCI-H716 [H716]细胞1984年建系,源自一位33岁患有大肠腺癌男性经5-fu治疗后的腹水中得到的细胞建立的细胞株。NCI-H716 [H716]细胞与其它结直肠癌细胞系不同,它有多巴脱羧酶,细胞质中有核心致密的内分泌型颗粒。NCI-H716 [H716]细胞不表达TAG-72或CA19-9抗原,也不生成癌胚抗原(CEA)。 | |||
| STR位点 | Amelogenin:X;CSF1PO:11;D13S317:8,11;D16S539:11,12;D18S51:15,16;D19S433:15,18.2;D21S11:32.2;D2S1338:14,16;D3S1358:D5S818:11.1;D7S820:10,11;D8S1179:12.2,14,15;FGA:20,22;TH01:6,9.3;TPOX:8,11;vWA:16; | |||
| 细胞代数 | 10代以内 | |||
| 生物安全等级 | 1 | |||
| 细胞规格 | 1×106cells/T25培养瓶或者1mL冻存管包装 | |||
| 支原体检测 | 无 | |||
| 保藏机构 | ATCC; CCL-251;中国医学科学院基础医学研究所细胞资源中心 | |||
| 培养基 | RPMI-1640+10%FBS+PS | |||
| 培养条件 | 气相:95%空气+5%二氧化碳;温度:37℃ | |||
| 冻存条件 | 无血清冻存液,液氮储存 | |||
| 倍增时间 | ~50 hours | |||
| 致瘤性 | Yes, in nude mice (Tumors developed within 21 days at 100% frequency (5/5) in nude mice inoculated subcutaneously with 1×10^7 cells). | |||
| 染色体 | 55~64 | |||
| 细胞货期 | 现货,1周左右 | |||
| 运输方式 | 复苏发货(T25瓶免运输费用)/ 冻存发货(需加干冰运输费用) 顺丰快递 | |||
| 供应限制 | 仅限于科学研究,绝不可作为动物或人类疾病的治疗产品使用 | |||
| 特别说明 | 以下细胞培养冻存处理仅供参考,具体操作步骤以随货产品说明书为主 | |||
| 二、细胞培养操作 | ||||
| 收货方式 | T25瓶 | 冻存管 | ||
| 收货处理 | 观察好细胞状态后,75%酒精消毒瓶壁,将T25瓶置于37度培养箱放置2-4h,以便稳定细胞状态 | 收到细胞后,需立即转入液氮冻存或直接复苏 | ||
| 传代密度 | 细胞密度达80%-90%,即可进行传代培养 | 第二天换液并检查细胞密度 | ||
| 传代比例 | 首次传代建议1:2传代 1:2传代就是1个T25瓶传2个T25瓶或者2个6cm皿。不是1个T25瓶传2个10cm皿 |
一管细胞建议接种到10cm培养皿或者T25瓶 | ||
| 传代方法 | 方法一:收集细胞,1000RPM条件下离心3-5min分钟,弃去上清液,补加1-2ml培养液后吹匀,将细胞悬液按1:2到1:4的比例分到新的含8ml培养基的新皿中或者瓶中。 方法二:可选择半数换液方式,弃去半数培养基后,将剩余细胞悬起,将细胞悬液按1:2到1:3的比例分到新的含8ml培养基的新皿中或者瓶中。 |
将含有1 mL细胞悬液的冻存管在 37℃水浴中迅速摇晃解冻,加4 mL培养基混合均匀。在1000 rpm条件下离心3 min,弃去上清液,加1-2 mL培养基后轻轻吹匀。然后将所有细胞悬液加入含适量培养基的培养瓶中培养过夜(或将细胞悬液加入6 cm皿中,加入约4 mL培养基,培养过夜)。第二天换液并检查细胞密度。 | ||
| 注意事项 | 1.运输用的培养基(灌液培养基)不能再用来培养细胞,请换用按照说明书细胞培养条件新配制的完全培养基来培养细胞。 2.因运输问题,部分细胞由于温度变化及剧烈碰撞死亡破碎形成碎片,是正常现象。 |
1.收货时若发现干冰化完,检查冻存管是否融化,若已融化需直接离心细胞接种观察,若未融化可以将细胞按正常步骤保存; 2.为保证细胞的高存活率,收到产品后,请立即解冻复苏细胞。 |
||
| 到货须知 | 1.收到细胞后,首先观察并拍照记录细胞瓶是否完好,培养液是否有漏液、浑浊等现象,干冰运输的细胞检查干冰是否完全挥发,细胞是否解冻,若有上述现象发生请及时和我们联系。 2.静置完成后,取出细胞培养瓶,镜检、拍照(当天以及第 2,3 天请拍照),记录细胞状态 (所拍照片将作为后续服务依据);建议细胞传代培养后,定期拍照、记录细胞生长状态。 3.由于运输的原因,个别敏感细胞会出现不稳定的情况,请及时和我们联系,告知细胞的具体情况,以便我们的技术人员跟踪回访直至问题解决。 4.仔细阅读细胞说明书,了解细胞相关信息,如细胞形态、所用培养基、血清比例、所需细胞因子等,确保细胞培养条件一致,若由于培养条件不一致而导致细胞出现问题,责任由客户自行承担。 |
|||
| 备注:客户在细胞培养过程中,有任何技术问题可以拨打技术服务电话:13166061152,我们随时给予解答。 | ||||
| 三、细胞冻存操作 | ||||
| 冻存液配方 | 无血清冻存液,液氮储存 | |||
| 细胞密度 | 待细胞生长状态良好时,可进行细胞冻存。下面 T25 瓶为例 | |||
| 冻存方法 | a、收集细胞及细胞培养液,装入无菌离心管中,1000 rpm条件下离心4 min,弃去上清液,用PBS清洗一遍,弃尽PBS,然后进行细胞计数。 b、根据细胞数量对应加入无血清细胞冻存液,使细胞密度5×106~1×107/mL,轻轻混匀,每支冻存管冻存1mL细胞悬液,注意冻存管做好标识。 c、将冻存管放入-80℃冰箱,24 h后转入液氮灌储存。记录冻存管位置以便下次拿取。 |
|||
| 注意事项 | 冻存细胞转入液氮后及时复苏一管检查细胞冻存活性,若有异常,及时调整实验方案 | |||
| 四、售后服务 | ||||
| 重发标准 | 1.细胞运输途中遭遇的各种问题,细胞丢失、瓶身破损、培养液严重漏液等,重发; 2.收到细胞未开封,如出现污染状况,重发; 3.收到细胞3天内,发现污染问题,经核实后,重发; 4.常温发货的细胞静置 2 小时后,干冰冻存发货的细胞复苏 2 天后,绝大多数细胞未存活,经核实后,重发; 5.常温发货的细胞静置 22 小时并且未开封或干冰冻存发货的细胞复苏 2 天后,出现污染,经核实后,重发; 6.细胞活性问题,请在收到产品 3 天内给我们提出真实的实验结果,用台盼蓝染色法鉴定细胞活力,经核实后,重发; 7.视具体情况而定。 |
|||
| 不予重发 | 1.客户操作造成细胞污染,不重发; 2.客户严重操作失误致细胞状态不好,不重发; 3.非我们推荐细胞培养体系致的细胞状态不好,不重发; 4.细胞状态不好,未提供真实清晰的培养前 3 天的细胞状态照片,不重发; 5.细胞培养时经其它处理导致细胞出现问题的,不重发; 6.收到细胞发现问题与客服人员沟通的时间证明大于3天的,不重发; 7.视具体情况而定。 |
|||

特别提示:本公司的所有产品仅可用于科研实验,严禁用于临床医疗及其他非科研用途!
风险提示:丁香通仅作为第三方平台,为商家信息发布提供平台空间。用户咨询产品时请注意保护个人信息及财产安全,合理判断,谨慎选购商品,商家和用户对交易行为负责。对于医疗器械类产品,请先查证核实企业经营资质和医疗器械产品注册证情况。
- 作者
- 内容
- 询问日期
文献和实验| STR位点 | Amelogenin:X;CSF1PO:11;D13S317:8,11;D16S539:11,12;D18S51:15,16;D19S433:15,18.2;D21S11:32.2;D2S1338:14,16;D3S1358:D5S818:11.1;D7S820:10,11;D8S1179:12.2,14,15;FGA:20,22;TH01:6,9.3;TPOX:8,11;vWA:16; | |||
来说,可通过 DNA 测序或 STR 技术来鉴定细胞系是否被污染。 3. 如何预防污染 对于细胞培养实验室来说,最重要的是杜绝一切可能的污染源。污染的来源可分为直接和间接两类。直接污染指使用试剂带来的污染或者所培养的细胞已经被污染。间接污染可能来自于实验室、实验设备或者我们自己本身。因此如何预防污染的发生是细胞实验室日常工作的重中之重。 如果实验室引入一种新的细胞,或者一直培养保存的细胞,但对保存细胞从未检测过,就有可能给实验室带来污染。因此使用前先检测新引入细胞株,或检测保存细胞是否纯净无污染
来计算MIC,值得注意的是该类仪器对抑菌圈内模糊生长或微小的菌落不能正确识别,而这些菌落对细菌的耐药性的判定至关重要,读取每个平板时必须进行人工观察。 (二)全自动的微生物鉴定和药敏试验分析系统 1.VITEK 系统 VITEK AMS是由生物-梅里埃公司生产的全自动微生物鉴定和药敏分析系统。第一代产品有以下四个规格VITEK AMS 32、60、120、240。由计算机主机、孵育箱/读取器、充填机/封口机、打印机等组成。鉴定原理是根据不同微生物的理化性质不同,采用光电比色法,测定
下,只有这两种蛋白同时存在时才表现出活性,mcrC具有识别和调节功能,它能特异性的结合到外源DNA上被甲基化的胞嘧啶(C)的特异序列G5mC上,然后由mcrB蛋白切断(mcrB蛋白是特异性切断外来DNA中G5mC序列的限制性核酸内切酶),防御外来DNA的侵入。mcrB, C基因的变异,使上述的对外来DNA的防御作用缺失,对质粒的转化有利。 mrr (Methylation requiring restriction) Map position: 98 min 功能:mrr基因是大肠杆菌细胞防御系统中







